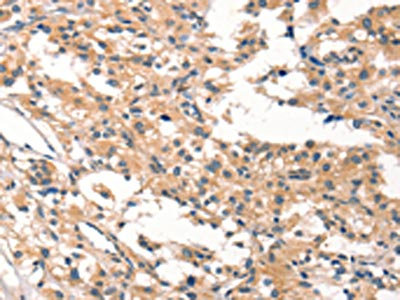

-
中文名稱:CYP46A1兔多克隆抗體
-
貨號:CSB-PA937671
-
規格:¥1100
-
圖片:
-
The image on the left is immunohistochemistry of paraffin-embedded Human brain tissue using CSB-PA937671(CYP46A1 Antibody) at dilution 1/15, on the right is treated with synthetic peptide. (Original magnification: ×200)
-
The image on the left is immunohistochemistry of paraffin-embedded Human thyroid cancer tissue using CSB-PA937671(CYP46A1 Antibody) at dilution 1/15, on the right is treated with synthetic peptide. (Original magnification: ×200)
-
Gel: 8%SDS-PAGE, Lysate: 40 μg, Lane: Human lymphoma tissue, Primary antibody: CSB-PA937671(CYP46A1 Antibody) at dilution 1/200, Secondary antibody: Goat anti rabbit IgG at 1/8000 dilution, Exposure time: 1 minute
-
-
其他:
產品詳情
-
Uniprot No.:
-
基因名:CYP46A1
-
別名:CYP46A1 antibody; CYP46Cholesterol 24-hydroxylase antibody; CH24H antibody; EC 1.14.14.25 antibody; Cholesterol 24-monooxygenase antibody; Cholesterol 24S-hydroxylase antibody; Cytochrome P450 46A1 antibody
-
宿主:Rabbit
-
反應種屬:Human,Mouse,Rat
-
免疫原:Synthetic peptide of Human CYP46A1
-
免疫原種屬:Homo sapiens (Human)
-
標記方式:Non-conjugated
-
抗體亞型:IgG
-
純化方式:Antigen affinity purification
-
濃度:It differs from different batches. Please contact us to confirm it.
-
保存緩沖液:-20°C, pH7.4 PBS, 0.05% NaN3, 40% Glycerol
-
產品提供形式:Liquid
-
應用范圍:ELISA,WB,IHC
-
推薦稀釋比:
Application Recommended Dilution ELISA 1:1000-1:2000 WB 1:200-1:1000 IHC 1:25-1:100 -
Protocols:
-
儲存條件:Upon receipt, store at -20°C or -80°C. Avoid repeated freeze.
-
貨期:Basically, we can dispatch the products out in 1-3 working days after receiving your orders. Delivery time maybe differs from different purchasing way or location, please kindly consult your local distributors for specific delivery time.
-
用途:For Research Use Only. Not for use in diagnostic or therapeutic procedures.
相關產品
靶點詳情
-
功能:P450 monooxygenase that plays a major role in cholesterol homeostasis in the brain. Primarily catalyzes the hydroxylation (with S stereochemistry) at C-24 of cholesterol side chain, triggering cholesterol diffusion out of neurons and its further degradation. By promoting constant cholesterol elimination in neurons, may activate the mevalonate pathway and coordinate the synthesis of new cholesterol and nonsterol isoprenoids involved in synaptic activity and learning. Further hydroxylates cholesterol derivatives and hormone steroids on both the ring and side chain of these molecules, converting them into active oxysterols involved in lipid signaling and biosynthesis. Acts as an epoxidase converting cholesta-5,24-dien-3beta-ol/desmosterol into (24S),25-epoxycholesterol, an abundant lipid ligand of nuclear NR1H2 and NR1H3 receptors shown to promote neurogenesis in developing brain. May also catalyze the oxidative metabolism of xenobiotics, such as clotrimazole.
-
基因功能參考文獻:
- the APOEepsilon4 alleles were significantly higher in patients with Alzheimer's disease (AD) and there was a potential synergistic interaction between the CYP46A1 C allele and APOEepsilon4 allele in AD. PMID: 29516283
- Data suggest that CYP46A1, the enzyme responsible for the majority of cholesterol elimination from the brain, exhibits activation by neurotransmitters, L-glutamate, L-aspartate, gamma-aminobutyric acid, and acetylcholine; L-glutamate-induced CYP46A1 activation may be of physiological relevance. PMID: 28642370
- CYP46A1 rs4900442 genetic polymorphism was associated with increased risk of Alzheimer disease in the Chinese population, but no evidences were detected in Caucasian population. PMID: 27026489
- Findings of this study suggest that CYP46A1 gene and PPARgamma2 gene polymorphisms can be a predictive marker for early identification of population at risk of primary open angle glaucoma (POAG). PMID: 27162448
- hippocampal CYP46A1 protein and 24S-hydroxycholesterol levels were reduced in a mouse model of Alzheimer's Disease-like Tau neuropathology PMID: 26358780
- under conditions of membrane cholesterol reduction by increased CYP46A1 expression, neurons increase isoprenoid synthesis and sGTPase prenylation. This leads to a reduction in liver X receptor activity PMID: 25084760
- Human CYP46A1 oxidizes 7-dehydrocholesterol to 24-hydroxy-7-dehydrocholesterol and 25-hydroxy-7-dehydrocholesterol. PMID: 25017465
- While there were no differences in cognitive performance between participants with and those without metabolic syndrome, ApoE and CYP46 genotypes did correlate with mental manipulation scores. PMID: 24924840
- results of meta-analysis suggested that CYP46A1 rs754203 is a minor risk factor for Alzheimer's disease PMID: 23792195
- An meta-analysis has successfully proved that CC genotype of the CYP46A1 T/C polymorphism could increase the risk of Alzheimer's disease. PMID: 23070465
- A meta-analysis indicates that the CYP46 gene SNP rs754203 is not significantly associated with sporadic Alzheimer's disease susceptibility in Chinese Han populations. PMID: 23167762
- To identify the determinants of tight azole binding to CYP46A1. PMID: 23604141
- analysis of binding of the cyano- and fluoro-containing drug bicalutamide to cytochrome P450 46A1 PMID: 23288837
- The intronic polymorphism in CYP46A1 is associated with Alzheimer disease in a Chinese Han population, and the CYP46A1 T allele might be a risk factor. PMID: 22528464
- The rs754203 C allele in the CYP46A1 gene may confer a higher risk for exudative age-related macular degeneration in patients who carry no risk alleles in the CFH and LOC387715 genes. PMID: 22977134
- Differentiated Ntera2/clone D1 (NT2) cells express the key genes involved in brain cholesterol homeostasis including CYP46A1. PMID: 22185844
- There was no association between the CYP46 genotype and measures of cognitive event-related potentials. PMID: 21729100
- Study of two independent Chinese data sets indicates individuals with CYP46A1 promoter bearing the CG haplotype are genetically more susceptible to Alzheimer's disease than those with TA haplotype. PMID: 20693622
- The data of this study suggested that CYP46 T/C SNP modulates parahippocampal and hippocampal morphology in young subjects. PMID: 19647891
- The rs754203 polymorphism itself is unlikely a genetic risk factor for primary open angle glaucoma in Caucasian individuals. PMID: 21386929
- The average P450 concentrations/mg of total tissue protein were 345 fmol of CYP46A1 and 110 fmol of CYP27A1 in the temporal lobe, and 60 fmol of CYP46A1 and 490 fmol of CYP27A1 in the retina. PMID: 21049985
- Structural basis of drug binding to CYP46A1, an enzyme that controls cholesterol turnover in the brain. PMID: 20667828
- Cholesterol 24-hydroxylase (CYP46A1) polymorphisms are associated with faster cognitive deterioration in Chinese older persons PMID: 19212968
- These results suggest that a disturbance of cholesterol metabolism may contribute to loss of EAAT2 in AD. PMID: 20193040
- In addition to its involvement in cholesterol homeostasis in the brain, CYP46A1 has a broad substrate specificity and is able to metabolize neurosteroids and drugs that can cross the blood-brain barrier and are targeted to the central nervous system. PMID: 14640697
- Polymorphisms in the CYP46 gene are found not to be risk factors for Alzheimer's disease nor are they associated with parenchymal or vascular accumulation of amyloid-beta protein. PMID: 15106838
- The distribution of CYP46 genotypes was significantly different in AD compared to controls and the CYP46 and ApoE polymorphisms synergically increase the risk for AD development. PMID: 15165699
- In contrast to two previous reports but in accordance with one other, we were unable to detect an association between an intron 2 polymorphism of CYP46 and Alzheimer disease. PMID: 15172102
- the polymorphism of CYP46 intron 2 is implicated in the susceptibility to late-onset Alzheimer's disease and a strong synergistic interaction between CYP46 TT homozoygots PMID: 15450677
- The GG genotype of the known rs754203 polymorphic site might be a risk factor for AD, especially in APOE varepsilon4 carriers. Interestingly, in AD patients the rs754203 G allele was more frequent in males than in females. PMID: 15936520
- Based on the results of genome-wide screens, along with biological studies, we selected three genes as candidates for AD risk factors: ATP-binding cassette transporter A1 (ABCA1), cholesterol 25-hydroxylase (CH25H) and cholesterol 24-hydroxylase (CH24H). PMID: 16157450
- Polymorphism was associated with the risk of Alzheimer disease(AD) but subjects homozygous for the C alleles were protected from AD with an adjusted odds ratio. PMID: 16734927
- here was no significant difference in the genotype or allele frequencies for CYP46 gene between AD patients and controls. PMID: 17335784
- substantial substrate-induced conformational changes in CYP46A1 suggest that structurally distinct compounds could bind in the enzyme active site PMID: 18621681
- The expression of CYP46A1, as well as other cytochrome P450s involved in cholesterol homeostasis, are potently regulated by histone acetylation status. PMID: 19059217
- the substrate, cholesterol, enters CYP46A1 from the membrane PMID: 19161969
- From the logistic regression ananlsis of this stidy showed that the highest risk for was found for Alzheimer's disease individuals who co-inherited APOE epsilon4 allele, PRNP codon 129 homozygosity, PRND codon 174 Thr allele, and CYP46 rs754203 g allele. PMID: 19363267
- The rs754203 SNP in CYP46A1 was associated with a risk for POAG. This polymorphism was not associated with changes in plasma 24S-hydroxycholesterol. PMID: 19553612
顯示更多
收起更多
-
亞細胞定位:Endoplasmic reticulum membrane; Single-pass membrane protein. Microsome membrane; Single-pass membrane protein. Cell junction, synapse, postsynapse. Cell junction, synapse, presynapse. Cell projection, dendrite.
-
蛋白家族:Cytochrome P450 family
-
組織特異性:Expressed in brain. The mRNA was broadly distributed with higher levels in gray matter zones and lower levels in regions rich in white matter. Not detected in fetal sample but its expression increases linearly with age.
-
數據庫鏈接:
Most popular with customers
-
-
YWHAB Recombinant Monoclonal Antibody
Applications: ELISA, WB, IHC, IF, FC
Species Reactivity: Human, Mouse, Rat
-
-
-
-
-
-